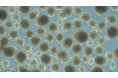
培養肉に向けて開発した国産牛由来の多能性幹細胞において3次元培養技術の開発に成功

プレスリリース一覧
- 表示切り替え

令和6年度 「酒サムライ」叙任者決定!!!
日本酒造青年協議会
美白で目指す「〇〇な肌」年代で違い。10代は白さ、20代はキメ、30代以降はシミ
聖心美容クリニック
株式会社アクリオ、人材紹介事業立ち上げ支援「人材紹介×スポットコンサル」サービスをリリース
株式会社アクリオ
千葉県旭市の商業施設「サンモール」内にベイシア Foods Park 旭サンモール店 9月12日(木)オープン 千葉県...
株式会社ベイシア
【紫宙3.0 PJ始動】1.5万円〜あなたが日本酒タンクオーナー?話題の日本酒「紫宙(しそら)」をクラファン出...
合同会社IW
株式会社アマナ、企業の広告宣伝担当者がプロジェクト発足時に活用できる「コミュニケーション施策与件整理シ...
株式会社アマナ
明利酒類の60年ぶりのウイスキー製造を、I&COがブランディングで支援
I&CO Tokyo
Microsoft SharePoint モダン UI 移行支援サービスを開始
ディスカバリーズ株式会社
「本当に本人が書いてる?」と疑われ…認知症で糖尿病の母、ダウン症の姉、酔っ払いの父…にしおかすみこが「パ...
株式会社講談社
小田急電鉄のマスコットキャラクター『もころん』とOJICOのコラボレーションTシャツが登場!
有限会社チャンネルアッシュ
【性感染症】吉原に「24H STD検査センター」オープン
株式会社メタボスクリーン
【メディア向け試食会を開催】「PIZZA&WINE ESOLA二子玉川店」が 9月7日(土)にグランドオープン!
GYRO HOLDINGS
培養肉に向けて開発した国産牛由来の多能性幹細胞において3次元培養技術の開発に成功
株式会社Hyperion FoodTech
マルハニチロのコミュニティサイト『Oishiine!!(おいしいね!!)』でゼライスレシピを共創
株式会社イーライフ
『【10社限定!ウェビナー実施にトライしたい企業様向け】』というテーマのウェビナーを開催
マジセミ株式会社
クリエイティブAIを提供するRADIUS5、AI似顔絵加工も可能なカンタンAI編集アプリ「Morich(モリッチ)」をリ...
株式会社 RADIUS5
テクノアが「共創モデル」構築を発表。自社パッケージシステムにとどまらないソリューション提案で日本の中小...
株式会社テクノア
【新商品】『コンパクトサイズ』泡のハンドソープ発売!
株式会社switch
<参加費無料・社長限定>オープンセミナー「酒のつまみになるぶっちゃけ話」開催のお知らせ【あいわ税理士法...
IR Robotics
<SES企業向け/採用ウェビナー>2024年9月12日(木)に「エンジニア採用術~年間100名以上を採用するための施...
(株)エージェントグロー
パルクール、ダブルダッチ、インラインスケートを全部体験しちゃおう!三井ショッピングパーク ららぽーと湘...
株式会社Xcountry
9/13(金) 〜 9/15(日) 開催!岸和田だんじり祭ビューイングシート(観覧席)発売のお知らせ
JAPAN NIGHT
【抽選で50名様にプレゼント】For-Denpoで『電報サマーキャンペーン』を実施!
株式会社プライムステージ
株式会社D-Chain、シードラウンド1stクローズにおいて7000万円超の資金調達を実施
株式会社D-Chain
ケップルキャピタルと浜松いわた信用金庫の事業承継ファンド、車のカスタマイズ・オーダーカスタム・パーツ販...
株式会社ケップルグループ
【明星 一平ちゃんが、たこ焼に!】新作『一平ちゃん夜店の焼そば味 たこ焼』数量限定8/28(水)発売決定!
株式会社ホットランドホールディングス
株式会社Oyraa、日本最大級の外国人材コミュニティを運営する株式会社Lincと業務提携を開始
株式会社Oyraa
KGモーターズ、損害保険ジャパン株式会社と持続可能な移動の実現に向けた協業に関する覚書を締結
KGモーターズ
株式会社アサヒ商会、「Swish」を導入して残業時間をほぼゼロに。オフィス提案業務を効率化して、お客様に更...
Swish
85年の信頼。麻生専門学校グループだからできる、企業連携で実現する高品質な人材教育
学校法人麻生塾
京都のヴィーガンカフェから「ヴィーガンわらびもちドリンク」を新発売
株式会社ヒューマンフォーラム
チャットボット「パスピア」でのマーケティング支援を造園会社「庭革命株式会社」が導入
株式会社パスピア
【事業立ち上げ力が身につく!!】「コンフィデンス大学」開校 - 27年1,050社以上の新規事業代行の実績に基づく...
株式会社コンフィデンス
株式会社オープンハウス・ディベロップメントがマンションの入居者向けインターネット回線の手数料にて「サブ...
株式会社ROBOT PAYMENT
9/9(月)サステナビリティ経営セミナー「インパクト雇用を人的資本経営につなぐ」開催と、グラミン日本理事...
一般社団法人グラミン日本
東京工業大学 超スマート社会推進コンソーシアム 第9回超スマート社会推進フォーラム開催決定!
東京科学大学 超スマート社会推進コンソーシアム事務局
【参加無料】超初学者向けの生成AI勉強会を開催【学生・社会人対象】
株式会社AI Forward
SmartDrive Fleet 全国安全運転イベントの開催について 【開催期間:2024年9月1日~9月30日】
株式会社スマートドライブ
製造業の「商談機会損失」をなくす。休眠顧客の掘り起しサービス「M-Reactivation(エム-リアクティベーショ...
株式会社メディックス
